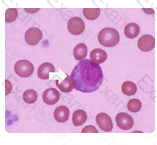
Question # 149

Pre-Summer Special Limited Time 70% Discount Offer - Ends in 0d 00h 00m 00s - Coupon code = getmirror
Pass the ASCP MLT(ASCP) ASCP-MLT Questions and answers with ExamsMirror
Exam ASCP-MLT Premium Access
View all detail and faqs for the ASCP-MLT exam
891 Students Passed
87% Average Score
92% Same Questions
In the laboratory, surfaces must be disinfected for blood spills. What is the most common disinfectant used?
After collection all blood should be stored at 1 - 6oC, unless it is going to be used as a source of platelets.
A refrigerator used to store whole blood must be able to maintain a temperature in the ranges of:
Animals serve as a reservoir of infection" is the correct answer because Shigella only infects humans while Salmonella is found in many animals. Both have diarrhea as the major symptom. Endotoxin is produced by all gram negative bacteria and exotoxin is only produced by Shigella.
A major difference between Salmonella enterica and Shigella infections is that only in salmonellosis can:
One agency that accredits education programs for clinical laboratory personnel is the:
The dematiaceous molds can be broadly separated into two major groups: the agents of chromomycosis that grow more slowly, maturing only after 7 days or more of incubation, and the more rapidly growing species that most commonly are clinically insignificant commensals or contaminants when recovered from clinical specimens, but in rare situations may cause opportunistic infections called phaeohyphomycosis.
Dematiaceous molds can be broadly separated into two major groups; the agents of chromomycosis and clinically insignificant commensals or contaminants. The agents of chromomycosis grow: more slowly than; more rapidly than; or generally at the same rate as the clinically insignificant commensals or contaminants?
Immunoassay is the most common technique that is used by clinical laboratories for therapeutic drug monitoring.
Most of the drugs commonly assessed with TDM can be measured on analytical platforms which utilize antibodies (in some form) for detection. Antibodies can be developed that recognize drugs. Although most drugs are much too small to evoke an immune response, scientists can conjugate drugs to immunogenic proteins to produce antibodies that recognize drug-specific epitopes.
Which of the following is the most common technique that is used by clinical laboratories for therapeutic drug monitoring?
Lavender stopper tubes can be used for all of the following except:
CD34, a cell surface marker, presents on undifferentiated pluripotential hemopoietic stem cells. CD34 is a cell surface glycoprotein and functions as a cell-cell adhesion factor.
Which one of the following antigen markers is BEST associated with stem cells?
Bacterial contamination of platelets is most likely because they are stored at room temperature.
Bacterial contamination is MOST likely in which of the following blood products?
To obtain a serum sample for a stat test on a patient receiving anticoagulant therapy, the recommended tube is:
Question options:
In combined fiscal years 2005 through 2009, transfusion-related acute lung injury (TRALI) caused the higest number of reported fatalities (48%), followed by hemolytic transfusion reactions (26%) due to non-ABO (16%) and ABO (10%) incompatibilities. Complications of microbial infection, transfusion-associated circulatory overload (TACO), and anaphylactic reactions each accounted for a smaller number of reported fatalities.
The best course of action when entering an isolation room is:
1. B
2. D
3. A
4. C
Red to Brown Urine: porphobilinogen, hematuria, myoglobinuria, etc.
Green: Food colorings; Increased carotene in the diet;
Pseudomonas aeruginosa infection
Yellow: bilirubin, bile pigments
White: phosphates, other crytals
Match urine color with substance that might have been responsible:
1. Phosphates
2. Bilirubin
3. Pseudomonas
4. Porphobilinogen
The cell shown in this image is a myelocyte. Myelocytes typically have an eccentric nucleus with cytoplasm similar to a mature neutrophils with a slightly bluer tint due to the cell's immaturity.
Myelocytes have both primary and secondary granules present in the cytoplasm. The nucleus is less mature and therefore has a loose chromatin clumping pattern.
Identify the cell in this illustration indicated by the arrow:
The anticoagulant present in a light-blue stopper tube is:
TOP CODES
Top selling exam codes in the certification world, popular, in demand and updated to help you pass on the first try.